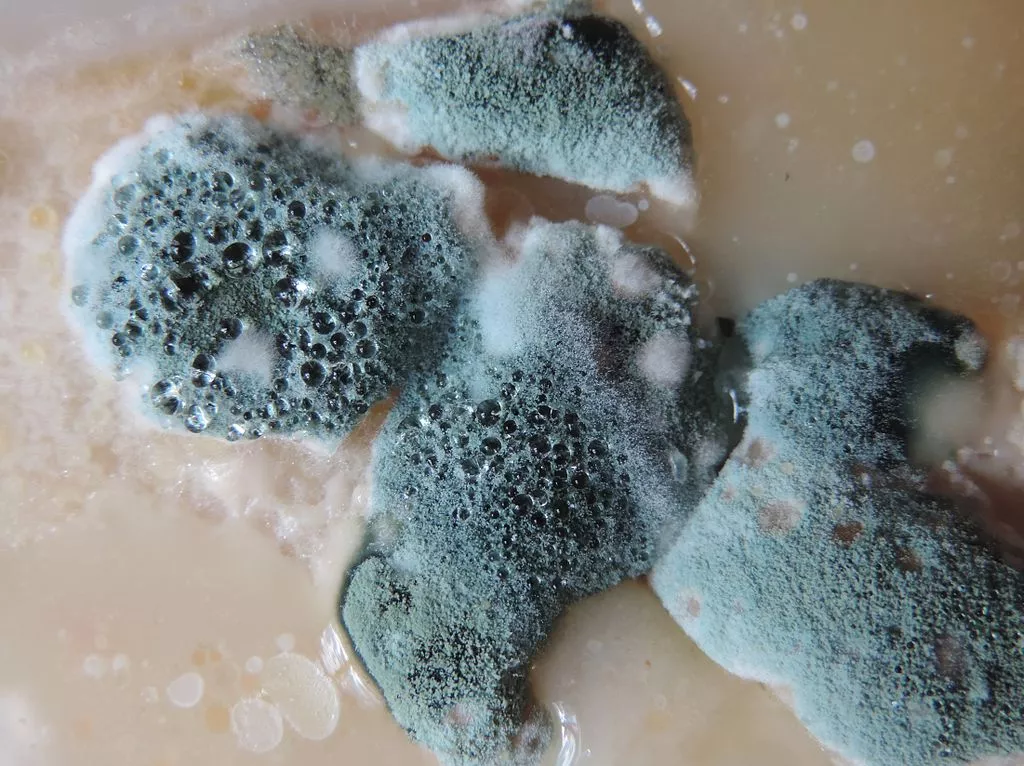
Mold

Many people can’t be bothered with switching off their car’s electrical features prior to turning off the engine. Most (if not all) of these amenities such as the radio and climate control automatically turn off anyway when the engine dies, so the ignition switch acts as a catch-all for everything that runs inside the car.

Turning the airconditioning to zero prior to engine shutoff is a good habit to cultivate
As a matter of convenience, there are those who would leave their airconditioning on before killing the engine. The likely belief behind this practice is that it does away with having to turn on the airconditioning again the next time the car is started (as if turning a dial or two was a tedious activity in itself, but we digress).
If you have developed a tendency to leave the aircon switches on between starting and stopping the engine, you might be wondering whether or not it carried serious, long-term consequences for your engine.

Most people prefer a centralized method of switching off electronics a.k.a. the starter button
Your car’s airconditioning/climate control system is composed of two parts: the blower and the thermostat. The former is powered by the electricity stored in the car’s battery, while the latter is enabled by the compressor, which is run directly by the car’s engine through a magnetic clutch.
This is the reason why you can get the fan running even if your ignition is in the ACC (accessory) position, but the engine has to be turned on if you want to cool down the cabin.
While it makes no difference whether the compressor is turned off or on by the engine, leaving the fan blower running places a load on the car’s battery. This normally isn’t an issue when the car has started since the alternator takes over upon ignition, or even when the battery is healthy in standby mode.
But when the battery is close to losing its charge, you’ll need every ounce of juice to crank up the engine, and constantly leaving the fan engaged only takes you that much closer to having a dead battery in your engine bay. And that’s not to mention the mold growing inside the cabin, due to the moisture caused by not giving the aircon vents ample time to dry out before turning off the engine.
>>> Related: 3 DIY tips to deal with moldy smells inside the car vents
The leftover moisture in your aircon provides a good breeding ground for molds in the cabin
>>> Related:
- List of popular car aircon repair shops in the Philippines
- Car Aircon Cleaning Service in the Philippines: Popular shops, Price & More
Engaging and disengaging the airconditioning through the ignition switch (as opposed to manually turning it on and off) isn’t going to have any long-term effects on the engine, as today’s compressors don’t sap nearly as much power from the engine as old ones did. But being diligent enough to set the air condition to zero before turning the engine off makes is a good habit to cultivate nonetheless.
We crank out the motoring tips at Philkotse.com.
Recent posts
- What are the car brands with the best aircon? Dec 23, 2022
- 9 steps to identify and solve potential problems in your car aircon system Aug 17, 2022
- 8 steps to eliminate odor from your car aircon system Aug 17, 2022
- Must-know tips for every Filipino driver to do a proper car aircon cleaning Apr 17, 2020
- 5 bad habits to discard when using car aircon system Mar 10, 2021